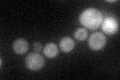
YML117W
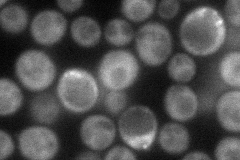
YML117W
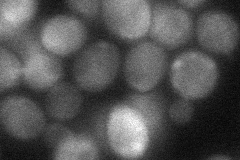
YML117W
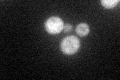
YML117W
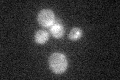
YML117W

View description
Putative RNA-binding protein that associates with mRNAs encoding cell wall proteins in high-throughput studies; deletion mutants display increased sensitivity to some cell wall disrupting agents; expression negatively regulated by cAMP
Localization:
Intensity:
Fold change:
Significance:
-
C’ GFP library in SD
cytosol34.54 -
N' NOP1pr-GFP in SD
cytosol71.0173 -
N' TEF2pr-mCherry in SD

cytosol61.2854 -
N' NATIVEpr-GFP in SD

cytosol,punctate38.1368 -
N' TEF2pr-VC and Cyto-VN in SD
cytosol38.1402 -
C’ GFP library in SD+DTT
cytosol34.460.99No -
C’ GFP library in SD+H2O2

cytosol31.650.91No -
C’ GFP library in Starvation Media
cytosol29.870.86No -
C’ GFP library on the background of Pup2-DaMP

cytosol -
C’ GFP library on the background of CCT mutant

cytosolN/AN/ANo
